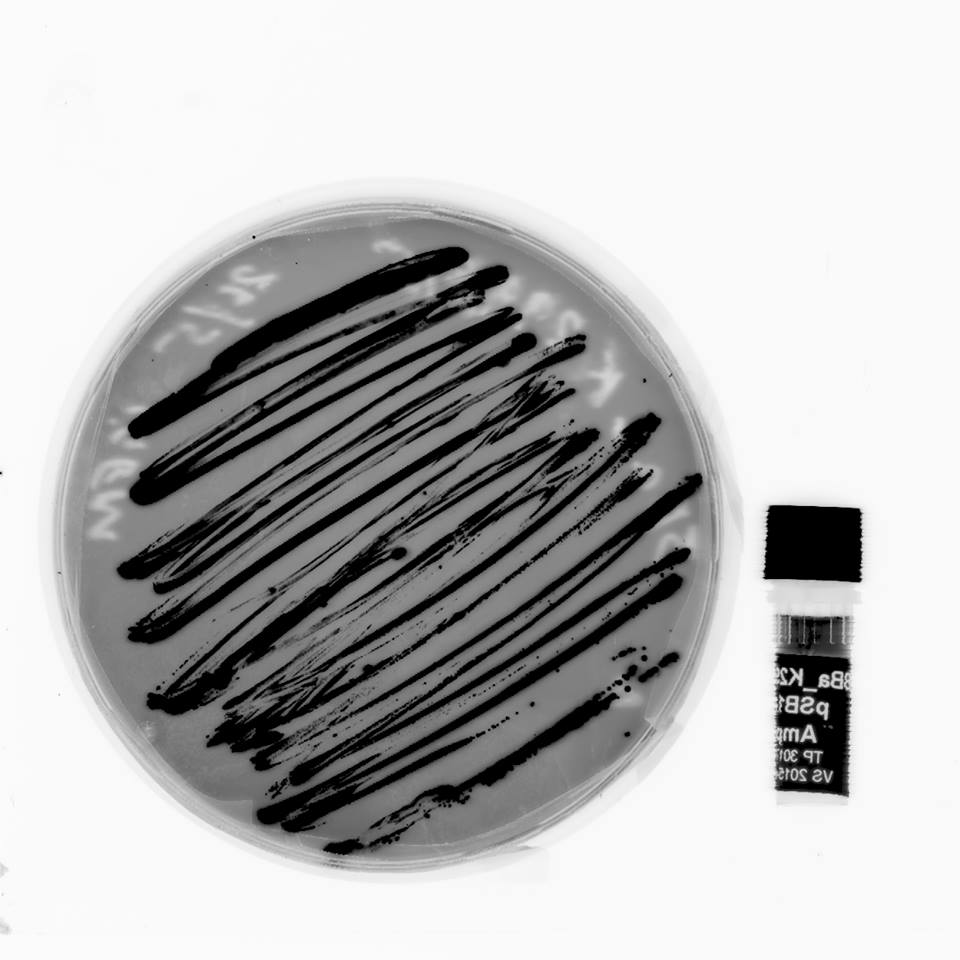
Mid year break is coming along nicely #unsw #iGEM

UNSW iGEM
@unsw_igem
We are the first ever UNSW team to enter iGEM, an international synthetic biology competition. See what we are up to and cheer us on!
ID: 3265829990
http://www.facebook.com/unswigemteam 02-07-2015 07:21:32
7 Tweet
105 Takipçi
21 Takip Edilen


Beautiful day at the Aus #iGEM meetup yesterday. Thanks to MQ iGEM 2015 Team & USyd for coming across the harbour x.com/MQ_AUST_iGEM/s…

Having a hard day in the lab so we were all keen for #gelatomessina.Apparently can't be delivered to Randwick. Disappointment Now Uber_Australia